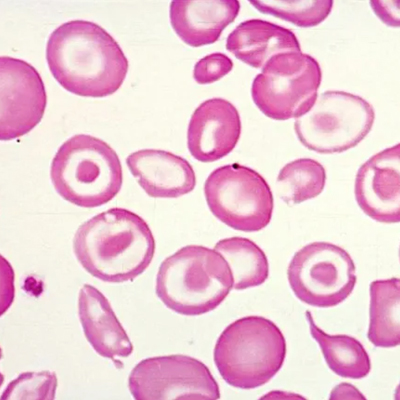

Timeless Ayurvedic Wisdom
Modern Scientific Research
Ayurvedic Approach – the Art of Understanding Oneself
Ayurveda is more than just a popular form of alternative medicine. It is a system of holistic healing unlike any other. Thought to be over five thousand years old, Ayurvedic medicine teaches us to see the world as it relates to the elements—or doshas —of vata , pitta , and kapha . The practice of Ayurveda as a medicine is believed to date back to over five thousand years, during the Vedic period of ancient India. Ayurveda represents a holistic and simple form of healing approach. It aims to know oneself and to reveal deeper causes of one’s health conditions. It strives to gain insight into the very core of a problem and discover the primary cause of the ailment. Ayurveda stands today as a global Indian icon. Overall, in Ayurveda, aging and longevity are seen as important aspects of overall health and well-being.



Ayurveda Treatment
Pure Ayurveda. Pure Healing.
Discover the Root Cause of Your
Health Concerns
As per Ayurveda, every individual is unique and so is their health condition. At VRVedas, we provide personalized Ayurvedic therapies focused on identifying the root cause of your health concerns. Our expert Vaidyas design natural, holistic treatment plans to restore balance and promote long-term wellness from the comfort of your home.

Why Choose VRVedas Treatment ?

Latest Announcements
Key updates, events, and important information.
What Our Patients Say
Authentic feedback from those who trusted our Ayurvedic care.

I consulted VRVedas Treatment for long-standing digestive issues. The doctors focused on the root cause and provided a personalized Ayurvedic treatment plan. The results were natural and effective.
The online consultation process was smooth and detailed. The Vaidya explained everything clearly and suggested the right herbal formulations. Very professional Ayurvedic service.

VRVedas Treatment offers holistic Ayurvedic care rather than temporary solutions. The treatment helped me improve my overall wellness without side effects. Highly recommended.